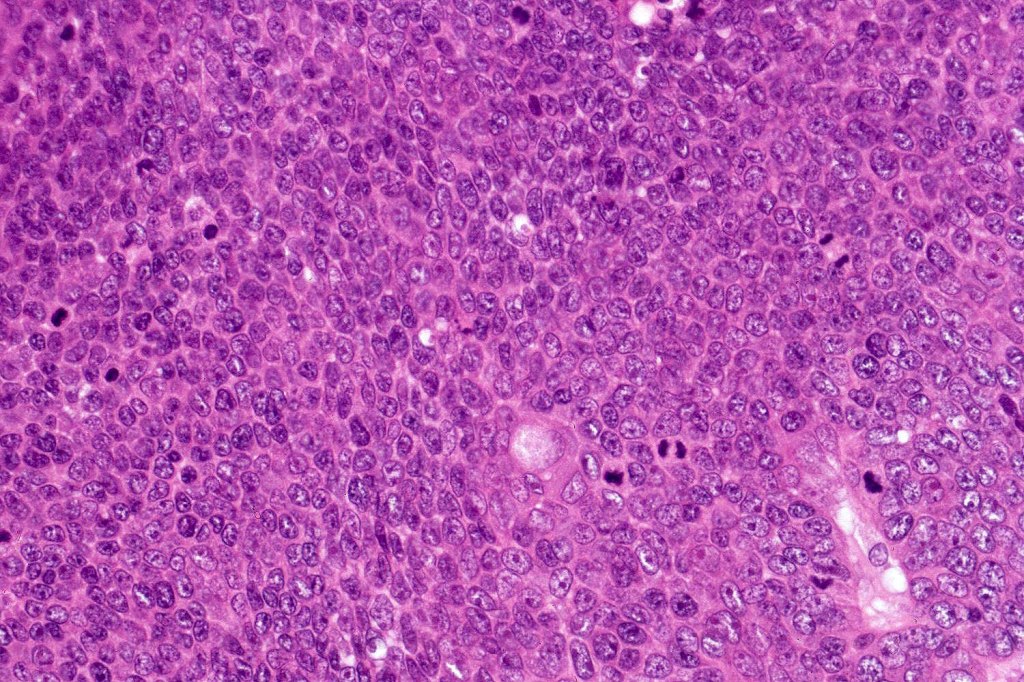

Clinical features
•Slowly growing, 0.5-3 cm hard nodule
•Cheek is the commonest site but may also present elsewhere on the head, neck, trunk & limbs
•Two age peaks- childhood and the elderly
•Sometimes tender
•Giant variant
•Familial multiple tumors (autosomal dominant)
•Rare syndromic associations (autosomal dominant- Gardner-, Turner-, & Rubinstein-Taybi syndromes & myotonic dystrophy


Histological features
•CTNNB1 gene mutations
•Differentiates towards follicular matrix
•Multilobulated tumor in dermis +/- subcutaneous fat with a fibrous pseudocapsule
•Basophilic small cells which transition towards supramatricial (orange staining) and ultimately ghost cells with intensely eosinophilic cytoplasm
•Intense mitotic activity may be seen in early lesions (this should not be interpreted as implying malignant potential)
. Focal clear cell change sometimes evident
•No abnormal mitoses or pleomorphism
•Late features include calcification and bone formation
•Foreign body reaction
•No perineural infiltration or lymphovascular invasion
•Pigmented variant & melanocytic matricoma
•Exceptional pseudocystic variant (tumor islands within a cystic cavity)
•Presence in hybrid cysts & other appendage tumors
•Rarely transepidermal elimination
•Proliferating pilomatricoma, seen in the elderly may show an infiltrating border, pleomorphism and abnormal mitoses (such a diagnosis should be used with extreme caution lest matricial carcinoma be missed)
.Keratin 5/6, bcl-2 β catenin, LEF1, PHLDA1 & Cyclin D1 +ve

Leave a comment